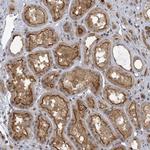
PSMG2 Antibody in Immunohistochemistry (Paraffin) (IHC (P))

Search
Invitrogen
PSMG2 Polyclonal Antibody
{{$productOrderCtrl.translations['antibody.pdp.commerceCard.promotion.promotions']}}
{{$productOrderCtrl.translations['antibody.pdp.commerceCard.promotion.viewpromo']}}
{{$productOrderCtrl.translations['antibody.pdp.commerceCard.promotion.promocode']}}: {{promo.promoCode}} {{promo.promoTitle}} {{promo.promoDescription}}. {{$productOrderCtrl.translations['antibody.pdp.commerceCard.promotion.learnmore']}}
产品信息
PA5-61301
种属反应
宿主/亚型
分类
类型
抗原
偶联物
形式
浓度
规格
纯化类型
保存液
内含物
保存条件
运输条件
RRID
产品详细信息
Immunogen sequence: IPGGGITKTL YDESCSKEIQ MAVLLKFVSE GDNIPDALGL VEYLNEWLQI LKPLSDDPTV SASRWKIPSS WRLLFGSGLP
Highest antigen sequence identity to the following orthologs: Mouse - 88%, Rat - 85%.
靶标信息
Chaperone protein which promotes assembly of the 20S proteasome as part of a heterodimer with PSMG1. The PSMG1-PSMG2 heterodimer binds to the PSMA5 and PSMA7 proteasome subunits, promotes assembly of the proteasome alpha subunits into the heteroheptameric alpha ring and prevents alpha ring dimerization.
仅用于科研。不用于诊断过程。未经明确授权不得转售。
篇参考文献 (0)
生物信息学
蛋白别名: CD40 ligand-activated specific transcript 3; HCCA3; HDCMC29P; hepatocellular carcinoma susceptibility protein; Hepatocellular carcinoma-susceptibility protein 3; HSPC260; likely ortholog of mouse CD40 ligand-activated specific transcript 3 (Clast3); MDS003; PAC-2; proteasome (prosome, macropain) assembly chaperone 2; proteasome a; proteasome assembling chaperone 2; Proteasome assembly chaperone 2; Tumor necrosis factor superfamily member 5-induced protein 1; unnamed protein product; x 003 protein
基因别名: CLAST3; HCCA3; HsT1707; MDS003; PAC2; PRAAS4; PSMG2; TNFSF5IP1
UniProt ID: (Human) Q969U7
Entrez Gene ID: (Human) 56984